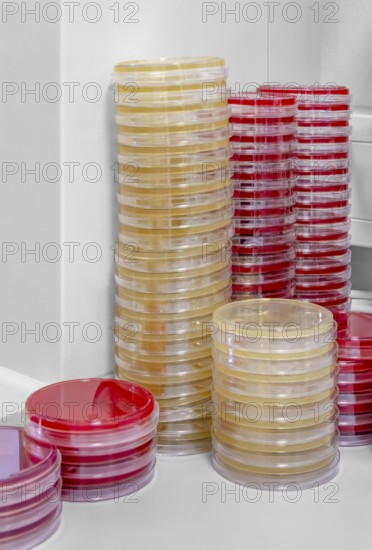

Légende
Lots of stacked petri dishes filled with colorful agar growth medium
Date
08 sept. 2018
Crédit
Photo12/imageBROKER/Achim Prill
Notre référence
BRK25J71_097
Model release
NA
Property release
Non
Licence
Libre de droits
Format disponible
44.0Mo (2.1Mo) / 27.3cm x 40.3cm / 3228 x 4764 (300dpi)